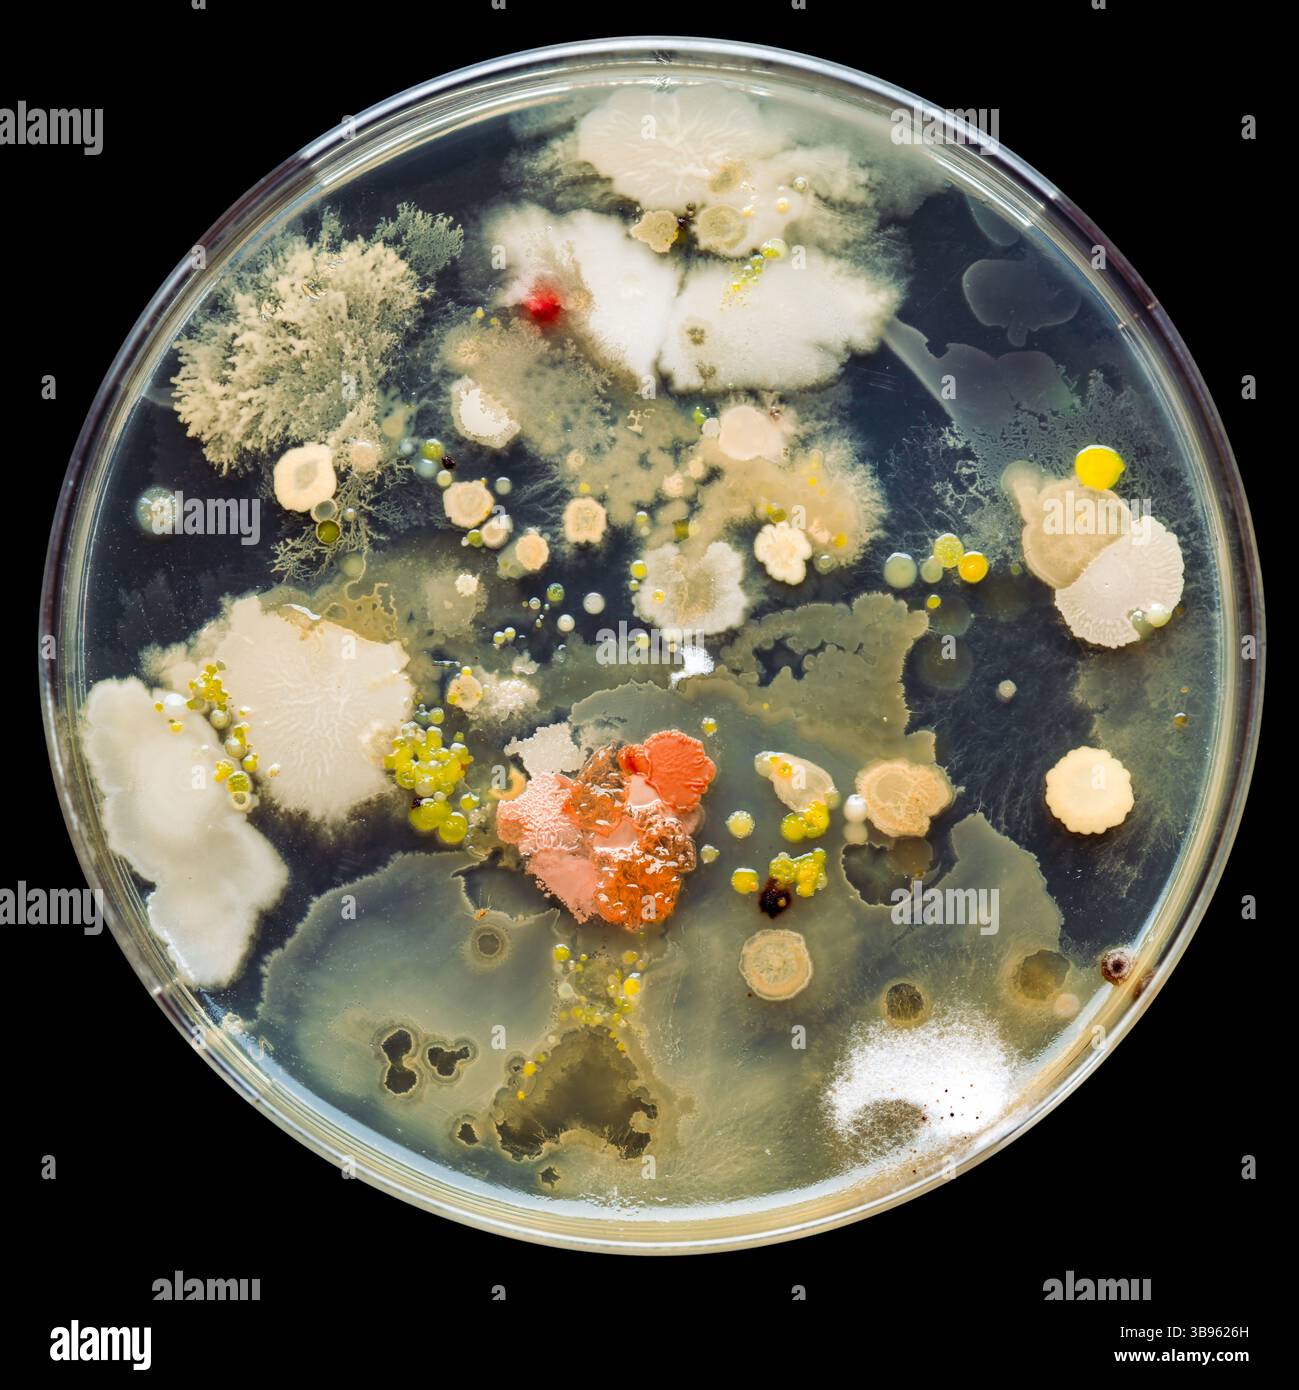
Petrischale gefüllt mit verschiedenen Bakterienkulturen. Wissenschaftliche Untersuchungen über die Gefahren von Keimen, bakteriellen Infektionen und tödlichen Krankheiten. Stockfoto
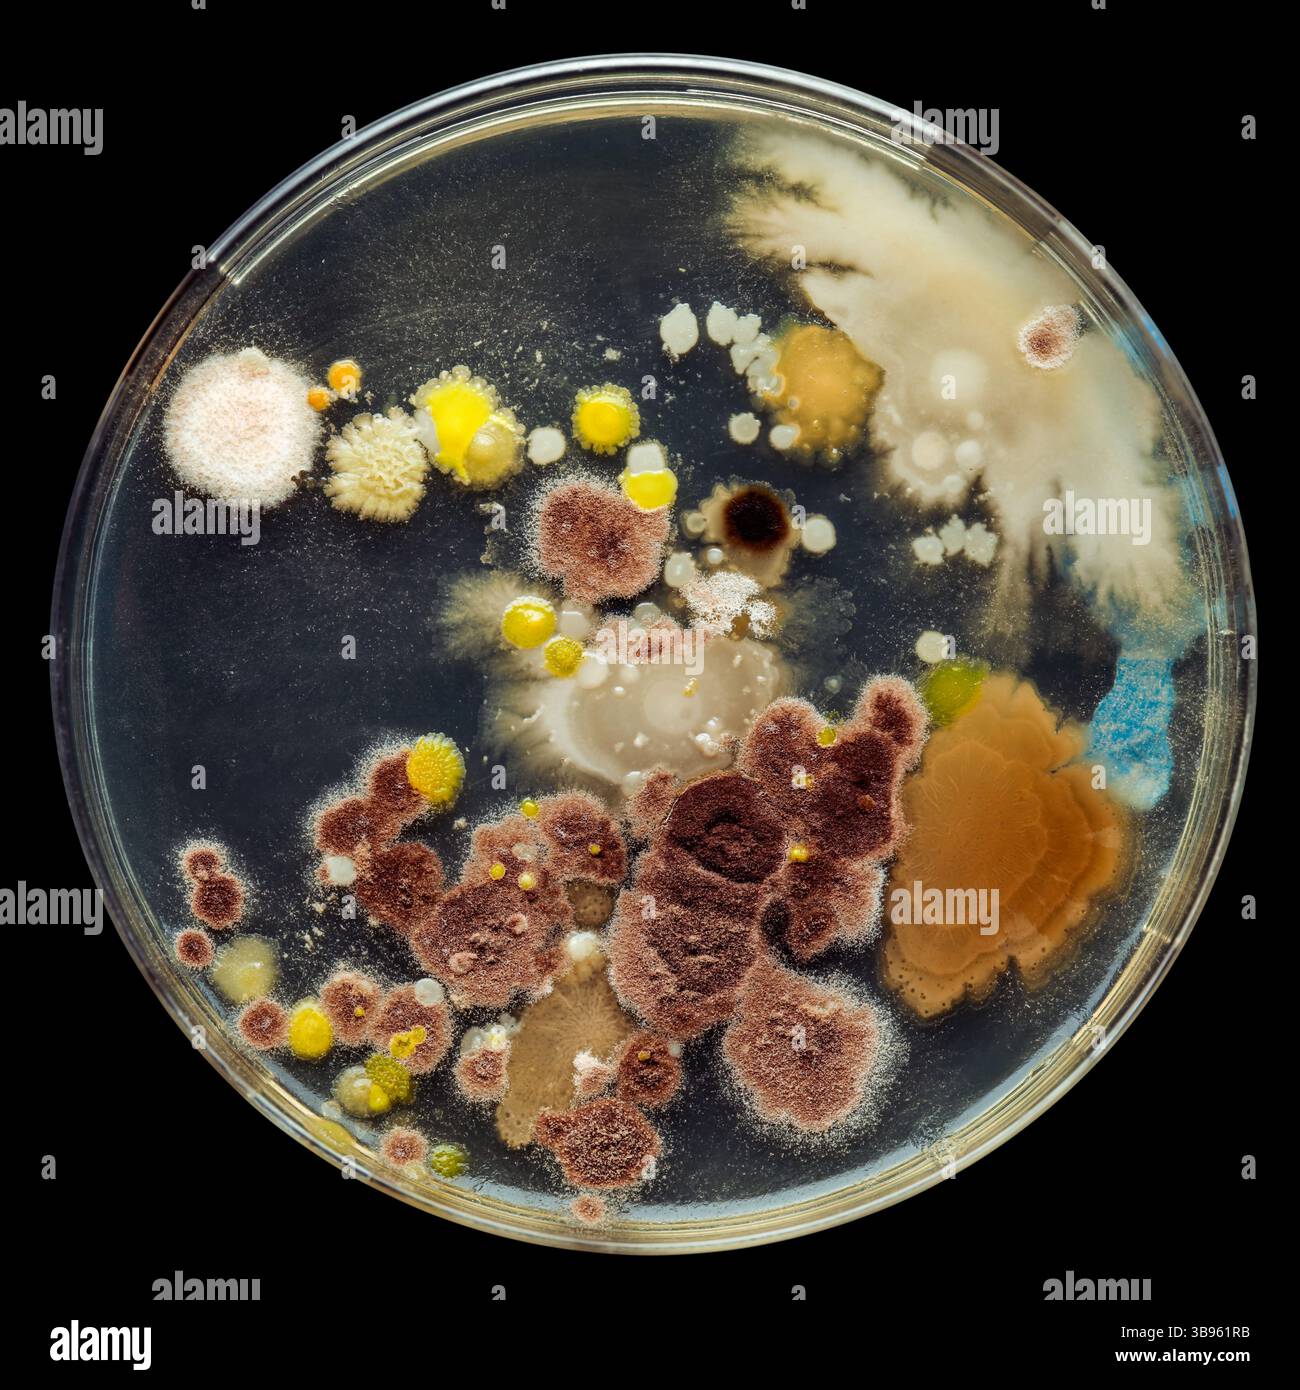
Petrischale gefüllt mit verschiedenen Bakterienkulturen. Wissenschaftliche Untersuchungen über die Gefahren von Keimen, bakteriellen Infektionen und tödlichen Krankheiten. Stockfoto
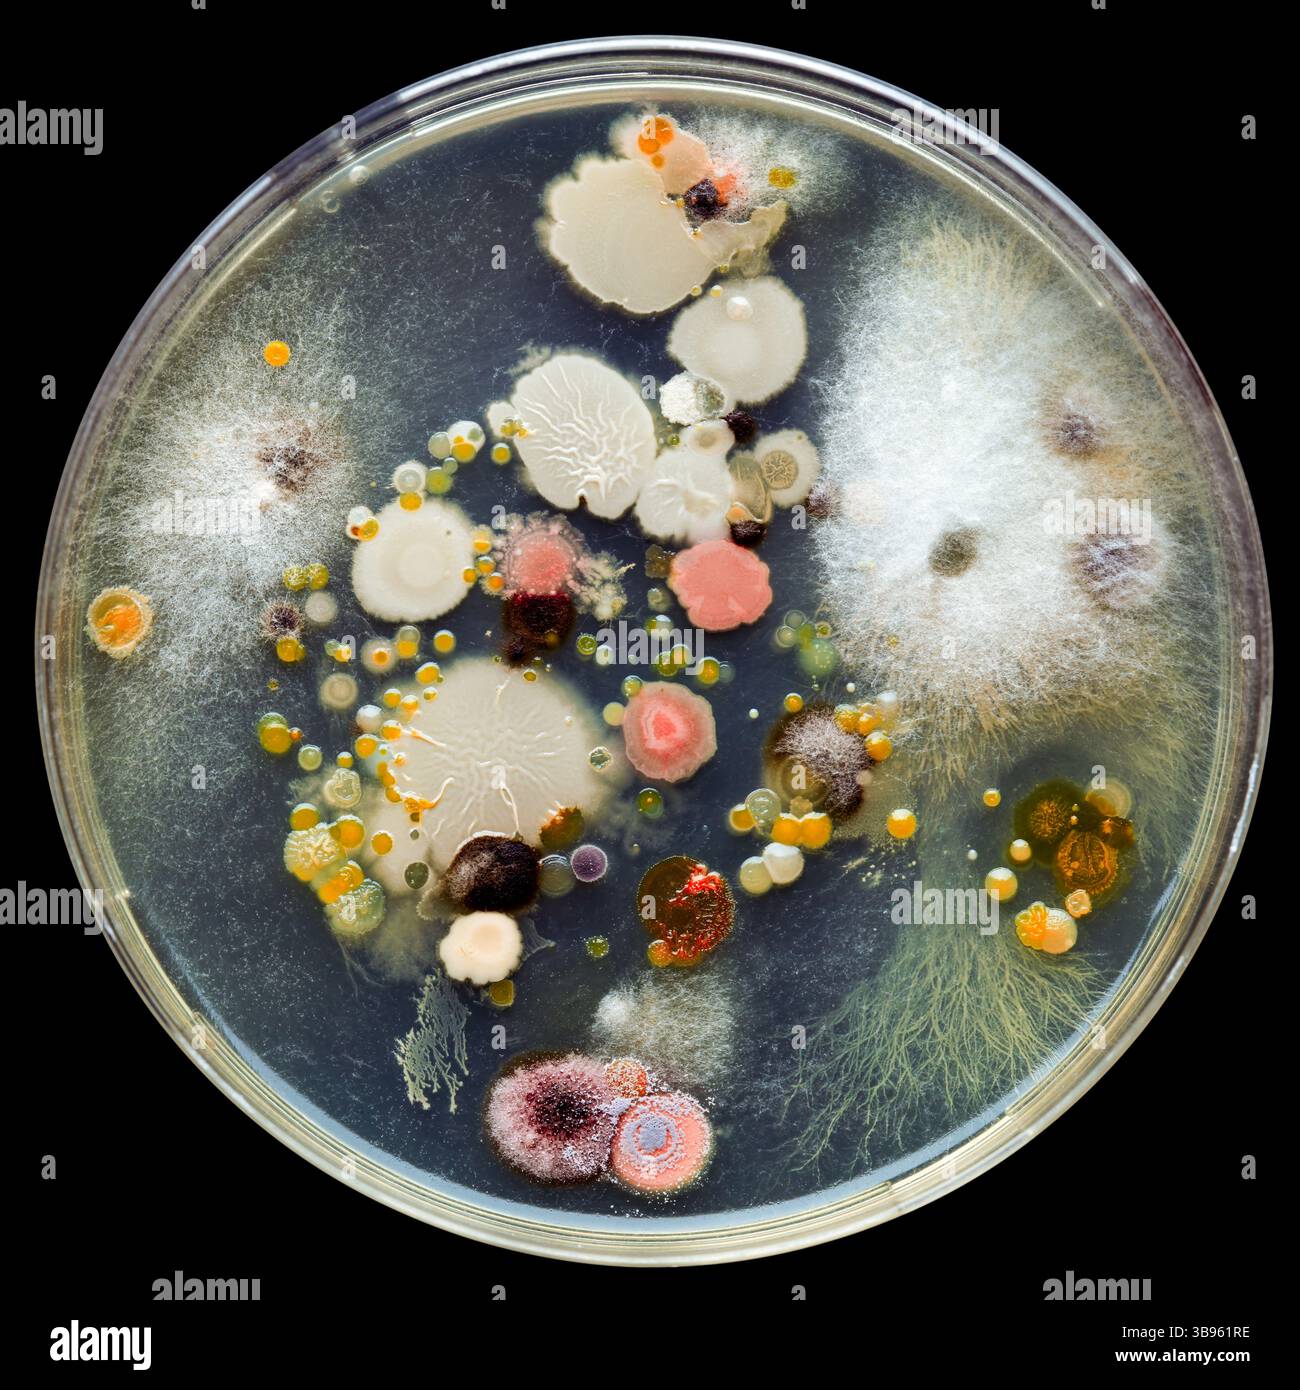
Petrischale gefüllt mit verschiedenen Bakterienkulturen. Wissenschaftliche Untersuchungen über die Gefahren von Keimen, bakteriellen Infektionen und tödlichen Krankheiten. Stockfoto

Schnellfilter:
Bacterial infections Stockfotos & Bilder

RMKTMMC4–Augmentin ist ein verschreibungspflichtiges Medikament, das Amoxicillin mit Clavulansäure kombiniert. Es wird zur Behandlung bakterieller Infektionen angewendet, indem es das Wachstum von Bakterien verhindert, die üblicherweise für Ohrinfektionen, Nasennebenhöhleninfektionen und Atemwegsinfektionen verschrieben werden.

RM2BEH40F–Ein molekulares Modell von Amoxicillin, ein Antibiotikum verwendet, um bakterielle Infektionen wie Streptose behandeln, Harnwegsinfektionen, Salmonellen, Lungenentzündung, und lyme-Borreliose. Amoxicillin wird leicht vom Körper absorbiert, so dass es eines der häufigsten Antibiotika verschrieben Patienten, und Funktionen durch Hemmung der Synthese von bakteriellen Zellwänden. Atome sind dunkelgrau (Kohlenstoff), hellgrau (Wasserstoff), rot (Sauerstoff), blau (Stickstoff) und gelb (Schwefel).

RME71M1W–Vancomycin ist ein Antibiotikum für die Behandlung einer Reihe von bakteriellen Infektionen.

RF2YKYJDP–Schlechte Hygiene führt zu bakteriellen Infektionen. Eine Metapher der Newton-Wiege, die zeigt, wie schlechte Hygiene bakterielle Infektionen auslöst. Ursache-Wirkung-Beziehung

RF2T3W9BY–Elefant Creeper Blume und Blatt wird für Wunden, Entzündungen, bakterielle Infektionen und andere Erkrankungen verwendet. Argyreia nervosa ist eine Bergsteigerin, die heimisch ist

RF2WD1N08–Streptokokkenbakterien und Streptokokkeninfektionen als grampositiver bakterieller Ausbruch als sphärische Streptokokkenzellteilung

RFJ9PTJF–Still-Leben dramatische Beleuchtung von Amoxicillin Tabletten ein-und Pakete für bakterielle Infektionen eingesetzt

RF2XCB18J–Illustration des Medikaments Avibactam (rot), das das bakterielle Enzym Beta-Lactamase (blau) hemmt. Avibactam wird in Verbindung mit Antibiotika zur Behandlung bakterieller Infektionen angewendet. Beta-Lactamase baut Beta-Lactam ab, ein integraler Bestandteil bestimmter Antibiotika, und kann somit Bakterien resistent gegen diese Antibiotika machen. Da Avibactam Beta-Lactamase hemmt, kann es diese Resistenz stören. Die molekulare Struktur von Avibactam (oben links) wird mit Atomen dargestellt, die als Kugeln dargestellt sind und farbcodiert sind: Kohlenstoff (grau), Wasserstoff (weiß), Sauerstoff (rot), Wasserstoff (blau) und Schwefel (gelb).

RMCYFN7H–Blister mit 250 mg Stärke Penicillin VK orale Antibiotische Tabletten gegen bakterielle Infektionen Ausschnitt und isoliert auf weißem Hintergrund

RFWT28A0–Entzündung durch bakterielle Infektionen im Blut verursacht Ursachen Koagulation Pathways in den Blutgefäßen, die Unfähigkeit, oxyge zu verursachen

RF2C51XTW–Benzylpenicillin, chemische Struktur und Skelettformel von Penicillin G. Antibiotikum verwendet, um eine Reihe von bakteriellen Infektionen zu behandeln.

RFCRNC1C–30 Mcg Tetracyclin: zur Behandlung von bakterieller Infektionen durch das Wachstum und die Ausbreitung von Bakterien zu verhindern.

RF2DH781E–Otitis media ist eine Entzündung des Mittelohrs. Bakterielle Infektionen Krankheit. Nahaufnahme von Staphylococcus aureus. Menschliche Anatomie. Illustration

RF2C8MHP2–Huelva, Spanien - 23. Juli 2020: Amoxicillin Marke Normon. Es ist ein Penicillin-Typ Antibiotikum verwendet, um bakterielle Infektionen zu behandeln, indem es growt stoppen

RMFF73GX–Vier Medikamente Kapseln von Antibiotikum Rifampicin verwendet zur Behandlung bakterieller Infektionen, einschließlich Tuberkulose in einer Londoner TB-Klinik, England, UK.
RF3B9626H–Petrischale gefüllt mit verschiedenen Bakterienkulturen. Wissenschaftliche Untersuchungen über die Gefahren von Keimen, bakteriellen Infektionen und tödlichen Krankheiten.

RMKTMMC5–Augmentin ist ein Kombinationsantibiotikum, das Amoxicillin und Clavulansäure enthält und zur Behandlung bakterieller Infektionen angewendet wird. Die Dosierung von 875 mg/125 mg wird häufig bei Erkrankungen wie Lungenentzündung, Bronchitis und Harnwegsinfektionen verschrieben. Es wirkt, indem es das Bakterienwachstum hemmt und die Wirksamkeit von Amoxicillin verbessert.

RME71M1T–Vancomycin ist ein Glycopeptide Antibiotikum in der Prophylaxe und Behandlung von Infektionen mit grampositiven Bakterien verwendet.

RF3BW47J1–Cefurax 500 mg Filmtabletten in einer Packung von Aristo Pharma GmbH. Orale Medikation zur Behandlung und Prophylaxe einer bakteriellen Infektion.

RMB5EDPT–Tabletten Co-Amoxiclav Antibiotika Penicillin, die eine Vielzahl von bakteriellen Infektionen zu behandeln, die was zu schweren Nebenwirkungen führen kann

RF2SAFPT9–Tuberkuloseinfektionsausbruch und TB-Ubertragung als ansteckende bakterielle Infektion durch Lungeninfektionen durch Mykobakterien

RFJ9PTNB–Still-Leben dramatische Beleuchtung von Amoxicillin Tabletten ein-und Pakete für bakterielle Infektionen eingesetzt

RF2XCB18D–Illustration des Medikaments Avibactam (rot), das das bakterielle Enzym Beta-Lactamase (blau) hemmt. Avibactam wird in Verbindung mit Antibiotika zur Behandlung bakterieller Infektionen angewendet. Beta-Lactamase baut Beta-Lactam ab, ein integraler Bestandteil bestimmter Antibiotika, und kann somit Bakterien resistent gegen diese Antibiotika machen. Da Avibactam Beta-Lactamase hemmt, kann es diese Resistenz stören. Die molekulare Struktur von Avibactam (oben links) wird mit Atomen dargestellt, die als Kugeln dargestellt sind und farbcodiert sind: Kohlenstoff (grau), Wasserstoff (weiß), Sauerstoff (rot), Wasserstoff (blau) und Schwefel (gelb).

RME679FK–Blisterpackung mit Flucloxacillin 500 mg orale antibiotische Kapseln mit Penicillin für die Behandlung von bakteriellen Infektionen.

RMCEBPG6–Doxycyclin 100 mg Kapseln Antibiotikum in Blindenschrift kodiert, das normalerweise als ein Anti-malaria-oder für bakterielle Infektion vorgeschrieben

RF2S8FGNH–Ohrentropfen zur Behandlung bakterieller Infektionen im äußeren Gehörgang oder Otitis externa.

RF3CP9M3X–Karton ARBEKACIN Tabletten auf einem Krankenhaus Apothekentisch zur Behandlung bakterieller Infektionen ein Aminoglykosid-Antibiotikum.

RF2DH781J–Das Ohr des Schwimmers. Otitis externa ist eine Entzündung des Gehörgangs. Bakterielle Infektionen Krankheit. Nahaufnahme von Pseudomonas aeruginosa. Menschliche Anatomie

RFRM9FJ7–Wenn der Körper immun Antwort auf bakterielle Infektionen, Entzündungen verursachen und undichte Blutgefäße im Körper.

RMFF72XR–4 Medikamente Kapseln von Antibiotikum Rifampicin verwendet zur Behandlung bakterieller Infektionen, einschließlich Tuberkulose in einer Londoner TB-Klinik, England, UK.
RF3B961RB–Petrischale gefüllt mit verschiedenen Bakterienkulturen. Wissenschaftliche Untersuchungen über die Gefahren von Keimen, bakteriellen Infektionen und tödlichen Krankheiten.

RMDYHXWD–Amoxicillin 500mg-Kapseln, ein häufig verschriebene Antibiotikum zur Behandlung bakterieller Infektionen.

RMD4BDEK–Fuß hat weit verbreitete Zerstörung menschlicher Gewebe durch bakterielle Infektion Diabetiker anfälliger bakterielle Infektionen als

RF3BP1BYA–SAP tritt aus Trauerkirsche aus, Zweige sterben, Krankheit Pilz- oder bakterielle Infektionen, Canker auf den Triebe eines Baumes in einem Obstgarten.

RMB550NB–Co-Amoxiclav Tabletten Antibiotika Penicillin, die eine Vielzahl von bakteriellen Infektionen zu behandeln, die was zu schweren Nebenwirkungen führen kann

RF2T65WK5–Phagen und Bakteriopage als Virus, das Bakterien infiziert als bakterielles virologisches Symbol als Erreger, der bakterielle Infektionen angreift.

RFJ9PTPE–Still-Leben dramatische Beleuchtung von Amoxicillin Tabletten ein-und Pakete für bakterielle Infektionen eingesetzt

RM2BFC0P9–Pharmazeutischer Arbeiter mit einer Flasche Cephalexin Cefalexin wird verwendet, um eine Reihe von bakteriellen Infektionen zu behandeln, einschließlich: Mittelohr-Infektionen, st

RMCYCNKX–Blindenschrift auf eine Schachtel mit Blisterpackung mit 250mg Stärke Penicillin VK orale Antibiotika-Tabletten bei bakteriellen Infektionen

RF2S8FGY6–Ohrentropfen zur Behandlung bakterieller Infektionen im äußeren Gehörgang oder Otitis externa.

RF3CP9M7D–Box AZTREONAM Tabletten auf einem Krankenhaus Apothekentisch verwendet, um bakterielle Infektionen zu behandeln ein Monobactam Antibiotikum.

RMW7PHMA–Bakterielle Canker der Aschen (Pseudomonas syringae ssp. savastonoi pv Fraxini). UK, Dezember.

RMFF72XK–4 Medikamente Kapseln von Antibiotikum Rifampicin verwendet zur Behandlung bakterieller Infektionen, einschließlich Tuberkulose in einer Londoner TB-Klinik, England, UK.
RF3B961RE–Petrischale gefüllt mit verschiedenen Bakterienkulturen. Wissenschaftliche Untersuchungen über die Gefahren von Keimen, bakteriellen Infektionen und tödlichen Krankheiten.

RMM05KCX–Der CAMP-Test ist ein labordiagnostisches Verfahren zur Identifizierung bakterieller Erreger, insbesondere von Streptokokken der Gruppe B (GBS). Es ist ein Schlüsseltest zur Beurteilung von Infektionen bei Neugeborenen und schwangeren Frauen.

RF2T3W9EY–Die Elefanten-Kriechblüte, auch bekannt als Vidhara Argyreia nervosa, ist eine Heilpflanze, die häufig im Ayurveda verwendet wird

RMDYHXX7–Amoxicillin 500mg-Kapseln, ein häufig verschriebene Antibiotikum zur Behandlung bakterieller Infektionen.

RMD4BDEB–Diabetiker anfällige bakterielle Infektionen wie hoher Blutzucker einige Komponenten Immunsystem hemmt Verlust gekoppelt

RF3BP1BRC–SAP tritt aus Trauerkirsche aus, Zweige sterben, Krankheit Pilz- oder bakterielle Infektionen, Canker auf den Triebe eines Baumes in einem Obstgarten.

RMB54KC4–Co-Amoxiclav Tabletten Antibiotika Penicillin, die eine Vielzahl von bakteriellen Infektionen zu behandeln, die was zu schweren Nebenwirkungen führen kann

RF2T674AM–Phagen und Bakteriophagen als Virus, das Bakterien als bakterielles virologisches Symbol als Erreger infiziert, der bakterielle Infektionen als Bakteriop angreift

RFJ9PTMK–Still-Leben dramatische Beleuchtung von Amoxicillin Tabletten ein-und Pakete für bakterielle Infektionen eingesetzt

RM2BFC0P5–Pharmazeutischer Arbeiter mit einer Flasche Cephalexin Cefalexin wird verwendet, um eine Reihe von bakteriellen Infektionen zu behandeln, einschließlich: Mittelohr-Infektionen, st

RMCYFN6P–Pillenflasche mit Flucloxacillin 500 mg oralen Antibiotikakapseln, die Penicillin-Medikamente zur Behandlung bakterieller Infektionen im weißen Großbritannien enthalten

RMCRX5TM–Eine Hand-Desinfektionsmittel-Spender und beachten die Menschen ermutigen, es im Kampf gegen Krankenhausinfektionen zu benutzen

RF2S8FGN9–Ohrentropfen zur Behandlung bakterieller Infektionen im äußeren Gehörgang oder Otitis externa.

RF3CP9PK5–Box mit CEPHALOSPORIN-Tabletten auf einem Krankenhaus-Apothekentisch verwendet, um bakterielle Infektionen zu behandeln ein Cephalosporin-Antibiotikum.

RF2PKH224–Palafolls, Barcelona/España; 04 12 2023: Ein Medikament, das als antiprotozoales und antibakterielles Mittel wirkt. Prophylaxe bakterieller Infektionen.

RM2HWXJ8N–30 Mcg Tetracyclin: zur Behandlung von bakterieller Infektionen durch das Wachstum und die Ausbreitung von Bakterien zu verhindern.

RF3B9626J–Petrischale gefüllt mit verschiedenen Bakterienkulturen in Form eines Schädels und Kreuzknochens, die die Gefahren von Keimen, bakteriellen Infektionen und DE zeigen

RM2PKA7MC–Untersuchungen über chronische bakterielle Infektionen innerhalb von Inserm. Student, der an bakteriologischen Infektionen arbeitet.

RM2DWC4PK–Hamburg, Deutschland. November 2016. Zum Themenservice-Bericht von Elena Zelle vom 23. Dezember 2020: Antibiotika können als Medikamente für viele bakterielle Infektionen eingesetzt werden. Quelle: Christin Klose/dpa-tmn/dpa/Alamy Live News

RMDYHXWW–Amoxicillin 500mg-Kapseln, ein häufig verschriebene Antibiotikum zur Behandlung bakterieller Infektionen.

RMD4BDEG–Diabetiker anfällige bakterielle Infektionen wie hoher Blutzucker einige Komponenten Immunsystem hemmt Verlust gekoppelt

RF2H7HJGD–Cassilandia, Mato Grosso do Sul, Brasilien - 11 20 2021: Amoxicillin Box auf portugiesisch ein Antibiotikum, das zur Behandlung einer Reihe von bakteriellen Infektionen verwendet wird

RF2BKCKPD–Hirsch tickt auf grünem Blatt. Ixodes ricinus oder scapularis. Nahaufnahme von parasitärer Milbe, die auf natürlichen Pflanzen kriecht. Träger von viralen und bakteriellen Infektionen.

RF2WYE206–Bakterien-Streptokokken- und Streptokokkeninfektionen als grampositiver bakterieller Ausbruch als sphärische Streptokokken-Zellteilung, die sich ausbreitet und wächst

RFJ9PTHF–Still-Leben dramatische Beleuchtung von Amoxicillin Tabletten ein-und Pakete für bakterielle Infektionen eingesetzt

RM2BFBHJ4–30 Mcg Tetracyclin: zur Behandlung von bakterieller Infektionen durch das Wachstum und die Ausbreitung von Bakterien zu verhindern.

RME679FH–Blisterpackung mit Flucloxacillin 500 mg orale Antibiotika-Kapseln Tabletten, die Penicillin-Medikamente zur Behandlung von bakteriellen Infektionen enthalten UK

RF2S8FD19–Hand-Halten-Genoint. Genoint ist ein Augentropfen, eine Augensalbe und eine Hautsalbe zur Behandlung von Entzündungen, die durch bakterielle Infektionen verursacht werden.

RF3CP9M7H–Box mit BACAMPICILLIN-Tabletten auf einem Krankenhaus-Apothekentisch verwendet, um bakterielle Infektionen zu behandeln ein Penicillin-Antibiotikum.

RF2BF4224–Eine Frauenhand wischt den Türgriff mit einem feuchten Lappen ab. Das Zimmermädchen wascht den Türknopf. Prävention von Coronavirus und bakteriellen Infektionen

RM2H5BK6R–pack von Metronidazole Tabletten Antibiotika verwendet, um eine Reihe von bakteriellen Infektionen zu behandeln - Antibiotika-Kapseln, Antibiotika-Pillen

RF2K37NNA–Cefepime Allgemeine Marken: Maxipime Antibiotika Es kann bakterielle Infektionen behandeln.

RF2PKB8BG–Untersuchungen über chronische bakterielle Infektionen innerhalb von Inserm. PhD-Student, der an Brucellose-Bakterien arbeitet.

RM2C5D1WX–Hamburg, Deutschland. April 2020. Zum Thema Servicebericht von Anja Sokolow vom 2. Juli 2020: Um bakterielle Infektionen im Gesicht zu vermeiden, sollte man seine Masken regelmäßig wechseln und waschen. Quelle: Mascha Brichta/dpa-tmn/dpa/Alamy Live News






















